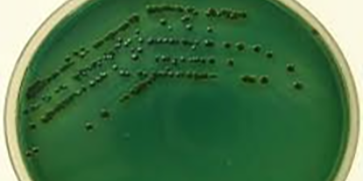

- Inicio
- Nosotros
- Historia
- Integridad Pública
- Órgano Interno de Control
- Comité de Ética e Investigación
- Comité Interno para el Cuidado y Uso de Animales de Laboratorio
- Unidad de Igualdad de Género
- Programa Institucional CIAD
- Normateca
- Compras y criterios de participación, Proveedores y Obra pública
- Información institucional
- Investigación
- COORDINACIONES
- Aseguramiento de Calidad y Aprovechamiento Sustentable de Recursos Naturales
Guaymas, Sonora - Ciencia y Tecnología de Productos Agrícolas para Zonas Tropicales y Subtropicales
Culiacán, Sinaloa - Acuicultura y Manejo Ambiental
Mazatlán, Sinaloa - Fisiología y Tecnología de Alimentos de la Zona Templada
Cuauhtémoc, Chihuahua - Tecnología de Productos Hortofrutícolas y Lácteos
Delicias, Chihuahua - Investigación y Desarrollo en Agrobiotecnología Alimentaria
Pachuca, Hidalgo - Unidad de Gestión Tecnológica
Tepic, Nayarit - Centro de Estudios e Investigación en Biocultura, Agroecología, Ambiente y Salud
Villa de Álvarez, Colima
- Aseguramiento de Calidad y Aprovechamiento Sustentable de Recursos Naturales
- INVESTIGACIÓN
- Posgrados
- Vinculación
- Contacto
- Inicio
- Nosotros
- Investigación
- COORDINACIONES
- Nutrición
- Ciencia de los Alimentos
- Tecnología de Alimentos de Origen Vegetal
- Tecnología de Alimentos de Origen Animal
- Desarrollo Regional
- Aseguramiento de Calidad y Aprovechamiento Sustentable de Recursos Naturales
Guaymas, Sonora - Ciencia y Tecnología de Productos Agrícolas para Zonas Tropicales y Subtropicales
Culiacán, Sinaloa - Acuicultura y Manejo Ambiental
Mazatlán, Sinaloa - Fisiología y Tecnología de Alimentos de la Zona Templada
Cuauhtémoc, Chihuahua - Tecnología de Productos Hortofrutícolas y Lácteos
Delicias, Chihuahua - Investigación y Desarrollo en Agrobiotecnología Alimentaria
Pachuca, Hidalgo - Unidad de Gestión Tecnológica
Tepic, Nayarit - Centro de Estudios e Investigación en Biocultura, Agroecología, Ambiente y Salud
Villa de Álvarez, Colima
- Personal de Investigación
- Grupos de investigación
- Proyectos vigentes
- Estancias posdoctorales
- COORDINACIONES
- Posgrados
 Convocatoria 2026-I
Convocatoria 2026-I- Oferta educativa
- Inscripciones/reinscripciones
- Cursos, grupos y horarios
- Calendario
- Servicios escolares
- Reglamentos y formatos
- Sistema Interno para el Fortalecimiento de los Posgrados (Sifor)
- Contraloría social
- Biblioteca
- Seguimiento de egresados
- Programa de iniciación a la investigación
- Movilidad estudiantil
- Prueba de Admisión
- TOEFL
- Aspirantes aceptados
- Directorio de Programas Académicos
- Vinculación
- Noticias
- Transparencia
- Contacto